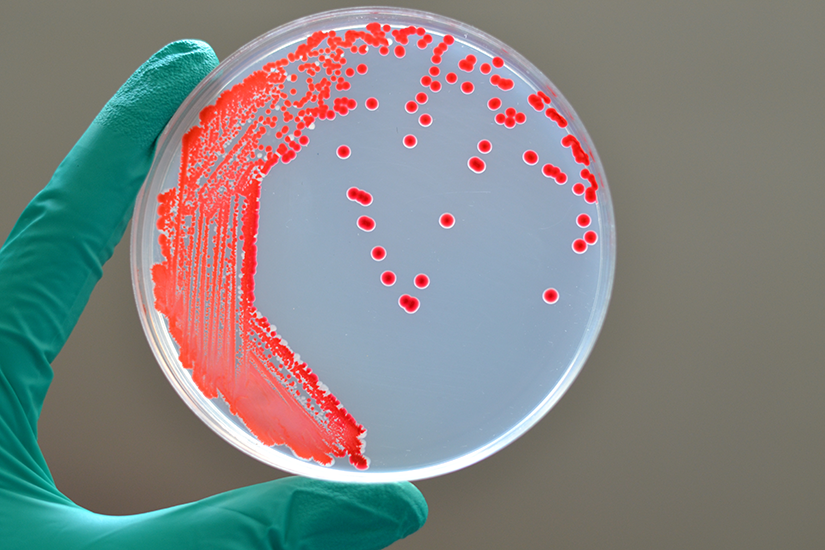
Infectia cu Serratia marcescens

Contactează-ne!
Ai simptome care te supără? Solicită chiar acum un sfat medical specializat.
Pe scurt despre bacteria cu Serratia marcescens
Patogen oportunist: Serratia marcescens afectează aproape exclusiv pacienții spitalizați prelungit, cu un sistem imunitar slăbit, cu boli cronice (diabet, cancer) sau care au dispozitive medicale invazive (catetere urinare, tuburi de respirație, catetere venoase, dializati)
Risc major în ATI: Reprezintă o amenințare critică în secțiile de Terapie Intensivă si Terapie Intensiva Neonatala, fiind al treilea cel mai frecvent patogen în focarele neonatale. La nou-născuți, o simplă colonizare poate progresa rapid către o infecție invazivă, cu risc major de meningită (infecție a creierului) și septicemie.
Mortalitate ridicată: Infecția sângelui (sepsisul) cu Serratia are o rată de deces de peste 25% în rândul pacienților vulnerabili.
Sursa: mediul umed: Bacteria se dezvoltă în biofilmul din sifoanele chiuvetelor, care acționează ca un rezervor persistent și poate dezvolta rezistența la dezinfectanții diluați utilizați în spital.
Calea de răspândire: Transmiterea majoră se face prin mâinile personalului medical, care iau bacteria de pe suprafețele contaminate (robinete, tejghea) cu aerosoli din sifonul contaminat.
Multirezistența la antibiotice: De multe ori, tulpina bacteriană este rezistentă la tratamentele standard, făcând eforturile medicilor aproape inutile, in special când dezvoltă rezistență la Carbapeneme (CRSM), antibioticele de ultimă linie.
Prevenție: Soluția stă în igiena strictă a mâinilor și în controlul riguros al surselor de apă și al sistemului hidric din spitale.
În acest articol, găsești tot ce trebuie să știi pentru a te proteja de infecțiile cu Serratia marcescens care pot deveni letale in anumite conditii de fragilitate a organismului.
Ce este Serratia marcescens?
Cine sunt pacienții cei mai expuși riscului de a se infecta cu această bacterie, în special în secțiile de Terapie Intensivă (ATI)?
Care sunt cele mai grave infecții pe care le provoacă Serratia marcescens și care este riscul de deces asociat?
Unde se ascunde bacteria în spital? Care este sursa ei principală și cum reușește să supraviețuiască dezinfectanților?
Cum se transmite bacteria de la sursa ei la pacienți?
Cum se depistează Serratia marcescens?
De ce este atât de dificil de tratat infecția cu Serratia?
Ce măsuri concrete pot lua spitalele (personalul medical) și ce pot face pacienții/vizitatorii pentru a preveni răspândirea ei?
Ce este Serratia marcescens?
Serratia marcescens este o bacterie Gram-negativă, din familia Yersiniaceae, ordinul Enterobacteriaceae, considerată un patogen oportunist. Interesant este că din aceeași familie face parte și Yersinia pestis, agentul cauzator al ciumei.
Deși se găsește natural în mediu (sol, apă, plante), în spital, Serratia marcescens profită de vulnerabilitatea pacienților pentru a provoca boli grave. Este o sursă importantă a infecțiilor asociate asistenței medicale (IAAM), cunoscute ca infecții nosocomiale.
- Serratia marcescens a fost descoperită în 1819 de către Bartolomeo Bizio în Italia. Timp de mulți ani a fost considerată nepatogenă, fiind notorie pentru pigmentul roșu (prodigiosina) pe care îl produce. Totuși, rolul său ca patogen uman a fost demonstrat încă din 1913, iar interesul științific a crescut după un focar nosocomial confirmat în 1951.
- Poate fi observată frecvent ca o peliculă roz-portocalie sau roșie în medii umede, cum ar fi în băi (pe rostru, în chiuvete, dusuri, vase de toaletă), hrănindu-se cu reziduuri care conțin fosfor sau grăsimi, cum ar fi săpunul.
Ce este o bacterie oportunistă?
Este un microorganism care, în mod obișnuit, nu provoacă probleme de sănătate și poate subzista inofensiv într-o regiune a corpului fără a cauza vreo boală.
Devine periculoasă și cauzează infecții (de unde și termenul "oportunistă") doar atunci când are ocazia, și anume când:
- Sistemul imunitar al gazdei (omului) este slăbit (de exemplu, din cauza unei boli cronice sau a unui tratament).
- Barierele naturale ale corpului sunt compromise (de exemplu, prin răni, arsuri sau prin introducerea unui dispozitiv medical invaziv, cum ar fi un cateter intravenos sau un tub de respirație în caz de ventilație mecanică).
Practic, profită de oportunitate pentru a pătrunde în țesuturi sau organe pe care în mod normal nu le-ar putea infecta. Serratia marcescens este un exemplu clasic de bacterie oportunistă.
Deși este cunoscută mai ales ca un patogen de mediu, Serratia marcescens poate coloniza diferite părti ale organismului:
- Tractul digestiv (intestinul): Aici poate coexista ca parte a florei microbiene normale, fără a provoca neapărat o boală.
- Tractul respirator superior: Poate coloniza mucoasa nazală sau faringiană.
- Pielea: Poate fi prezentă pe suprafața pielii, mai ales în mediul spitalicesc sau în zone umede.
Așadar, deși sursa majoră a infecțiilor severe este mediul înconjurător (sifoane, chiuvete, etc), bacteria poate face parte și din microbiomul uman, transformându-se în agent patogen in conditii propice.
Incidența infecțiilor cu S. marcescens
S. marcescens este în primul rând un agent patogen nosocomial (asociat spitalului), fiind o cauză frecventă a infecțiilor dobândite în unitățile sanitare (infecții asociate asistenței medicale - IAAM).
- Reprezintă aproximativ 1.4% din cazurile de IAAM în SUA și este un patogen important, mai ales în secțiile de Terapie Intensivă (ATI) și Terapie Intensivă Neonatală (ATIN), unde poate provoca focare severe.
- Studiile arată că Serratia spp. este al treilea cel mai frecvent patogen implicat în focarele din unitățile neonatale.
- Conform datelor de la Centrul European de Prevenire și Control al Bolilor (ECDC), Serratia spp. se plasează, în general. Pe locul al șaselea printre microorganismele izolate în cazurile de pneumonie dobândită în secțiile de Terapie Intensivă (ATI). Printre primele zece cauze de infecții ale fluxului sanguin (septicemie/bacteriemie) și infecții ale tractului urinar (ITU) în sectiile ATI.
- Pacienții imunocompromiși, cei cu boli cronice, cu dispozitive medicale invazive, precum și cei spitalizați pe termen lung prezintă un risc mult mai mare.
- Deși mai rar, pot apărea și infecții dobândite în comunitate, dar majoritatea cazurilor severe sunt de natură nosocomială.
Cine este cel mai expus riscului de infecție cu Serratia Marcenses in spital (grupurile de risc)?
- Nou-născuții din ATI: Sunt extrem de vulnerabili. Serratia este printre primii trei agenți patogeni implicați în focarele din secțiile de Terapie Intensivă Neonatală.
- Pacienții cu dispozitive invazive: Cei care au catetere venoase centrale, persoanele dializate, intubate (ventilatoare mecanice) sau cei cu sonde urinare (sonde Foley). Aceste dispozitive servesc ca poartă de intrare pentru bacterie și facilitează formarea unui biofilm rezistent, care protejează bacteria de antibiotice sau dezinfectanți uzuali.
- Vârstnicii: Peste 70% dintre cazurile de bacteriemie cu Serratia (bacterie prezentă în sange) afectează pacienții cu vârsta de 60 de ani și peste, cu boli cronice asociate.
- Pacienți imunocompromiși: Persoanele cu sisteme imunitare slăbite (ex. pacienții cu cancer, diabet zaharat, boli cronice, pacienții sub tratament imunosupresor).
Care sunt tipurile de infecții cu Serratia Marcensens și în ce constau simptomele principale?
Pentru că această bacterie poate afecta diverse zone ale corpului, manifestările clinice variază în funcție de locul infecției și de cât de grav este compromisă funcția organelor implicate.
- Infecții respiratorii (pneumonie): Apar frecvent la pacienții aflați sub ventilație mecanică. Simptomele includ febră, frisoane, tuse, dificultăți de respirație și spută cu nuanță rozalie.
- Infecții ale tractului urinar (ITU): Sunt comune la persoanele cu sondă urinară. Se manifestă prin durere sau disconfort la urinare, urină cu tentă rozalie (hematurie) și febră.
- Infecții ale pielii sau ale plăgilor chirurgicale: Se caracterizează prin roșeață, durere, secreție purulentă la nivelul plăgii și febră.
- Infecții oculare (ex. keratită – inflamația corneei): Simptomele includ roșeață și durere oculară.
- Infecții sistemice (septicemie/bacteriemie): Reprezintă forma cea mai gravă și potențial letală, adesea asociată cu utilizarea cateterelor venoase. Rata de mortalitate variază între 25% și 58%. Manifestările clinice includ febră, frisoane, letargie, tensiune arterială scăzută, iar în cazurile severe poate surveni șocul septic.
- Meningită (în special la nou-născuți): Această infecție rară, dar extrem de gravă, afectează meningele — membrana care învelește creierul și măduva spinării — și apare cu precădere la nou-născuți. Simptomele includ febră, rigiditate a cefei, fotofobie (sensibilitate la lumină), letargie și vărsături.
- Osteomielită și endocardită: Infecții rare, care apar mai frecvent la persoanele ce utilizează droguri intravenos.
Capcană în ATI. Cum se transmite Serratia Marcenses și care sunt rezervoarele de infecție?
Modul în care Serratia marcescens se răspândește în spital este esențial pentru înțelegerea lanțului de transmitere și pentru prevenție.
Colonizarea mediului (rezervoarele)
Serratia marcescens are o capacitate remarcabilă de a supraviețui și de a se dezvolta în medii umede și pe diferite suprafețe, în special cele care conțin materie organică sau urme de detergenți. Principalele rezervoare sunt:
Sistemul hidric
Sifoanele, chiuvetele, scurgerile de la dușuri și recipientele de colectare a apei reprezintă rezervoarele primare.
Bacteria se dezvoltă în apa care stagnează si formează un biofilm rezistent și aderent pe pereții interiori ai acestor conducte, protejându-se de dezinfectanți și de fluxul de apă.
Soluțiile (Dezinfectanți/Medicamentoase)
În mod ironic, S. marcescens a demonstrat rezistență la unii dezinfectanți obișnuiți (precum compușii cu amoniu cuaternar), ceea ce ii permite să supraviețuiască în soluțiile diluate sau pe suprafețele dezinfectate necorespunzător. De asemenea, au fost documentate cazuri de contaminare a soluțiilor intravenoase (IV) sau a soluțiilor de irigare.
Echipamentul medical
Suprafața externă a ventilatoarelor, nebulizatoarelor, termometrelor și, mai ales, a cateterelor (intravenoase și urinare), unde bacteria poate coloniza rapid și iniția infecția.
Calea de contaminare (mecanismul de răspândire)
Odata colonizat mediul, răspandirea se desfășoară cu usurinta, mai ales in contextul unei vigilente reduse a personalului medical.
- Aerosolizarea apei contaminate: Când se dă drumul la apă la chiuvetă, forța jetului poate expulza micro-picături de apă (aerosoli) din sifon în aer. Acești aerosoli contaminați se depun pe robinete și pe suprafețele umede din jurul chiuvetei, dusurilor, meselor, de unde bacteria se poate răspândi.
- Mâinile personalului: Bacteria este preluată de pe suprafețele contaminate (ex. mânerul robinetului) pe mâinile sau mănușile personalului medical și, de acolo, transferată direct la pacient în timpul îngrijirii sau manipulării dispozitivelor invazive.
- Echipamente medicale contaminate: Prin atingerea echipamentelor contaminate, cum ar fi cateterele, tuburile de ventilație, soluțiile intravenoase sau alte dispozitive invazive. Bacteria se poate atașa de suprafața acestor dispozitive (formând un biofilm) și poate pătrunde în organism.
- Rezistența la dezinfectanți: Tulpinile patogene, nosocomiale pot supraviețui și chiar prolifera în soluțiile diluate de dezinfectanți (în special în cele pe bază de compuși cu amoniu cuaternar), transformând dezinfectantul într-un mediu de cultură.
Diagnosticul infecției cu S. marcescens
Depistarea infecțiilor nosocomiale cu S. marcescens implică atât diagnosticul pacienților, cât și identificarea unui cluster (grup) de cazuri care indică un focar.
Diagnosticul pacientului cu S. marcescens
Diagnosticul de infecție cu S. marcescens se face prin metode microbiologice:
- Recoltarea de probe biologice: Se prelevează probe din locul presupus al infecției, în funcție de simptome:
o Sânge (Hemoculturi): Pentru depistarea septicemiei/bacteriemiei.
o Urină (Uroculturi): Pentru infecții urinare (ITU).
o Spută sau aspirat traheal: Pentru pneumonie sau infecții respiratorii.
o Exsudat din plăgi: Pentru infecții ale plăgilor chirurgicale sau cutanate.
o Lichid cefalorahidian (LCR): Pentru meningită. - Cultivare și identificare: Probele sunt însămânțate pe medii de cultură. Prezența bacililor Gram-negativi, urmată de testele biochimice specifice, confirmă specia Serratia marcescens.
- Antibiogramă: Deoarece S. marcescens este cunoscută pentru rezistența la multiple antibiotice, se efectuează obligatoriu antibiograma pentru a testa sensibilitatea tulpinii izolate la diferite medicamente.
- Screening-ul activ (în timpul focarului): În unitățile de risc (ATI, ATI Neonatal), se pot recolta probe de colonizare (tampon faringian, rectal, ombilical la nou-născuți) de la pacienții asimptomatici pentru a identifica purtătorii (rezervoarele) bacteriei și a preveni răspândirea.
Investigarea focarului S. marcescens (Epidemiologia)
Un focar este suspectat când apare un număr neobișnuit de cazuri de infecție cu același microorganism (sau tulpină) într-o anumită perioadă și zonă a spitalului.
- Tipizare moleculară (WGS, PFGE): Pentru a confirma că toate cazurile sunt cauzate de aceeași tulpină bacteriană, probele izolate de la pacienți sunt trimise la laboratoare de referință pentru tipizare moleculară (ex. secvențierea genomului - WGS sau Electroforeza în câmp pulsat - PFGE). Acest lucru confirmă legătura epidemiologică între cazuri.
- Screening de mediu și personal: Odată confirmat focarul, se prelevează probe din mediu (apă, chiuvete, scurgeri, suprafețe umede, echipamente medicale, soluții dezinfectante) și de la personalul medical (mâini) pentru a identifica sursa de contaminare.
Prevenirea și înlăturarea focarului Serratia marcescens
Prevenirea și controlul focarului se bazează pe un pachet de intervenții riguroase de control al infecțiilor nosocomiale (IPC - infection prevention and control).
Măsuri esențiale de prevenire (bază)
Acestea sunt măsuri standard care trebuie aplicate permanent:
- Igiena mâinilor (cea mai importantă): Respectarea strictă a celor 5 momente ale igienei mâinilor (cu apă și săpun plus soluții pe bază de alcool) de către toți membrii personalului medical.
- Curățenie și dezinfecție de înaltă calitate: Curățarea temeinică, zilnică și regulată a tuturor suprafețelor, în special în zonele umede (băi, chiuvete, scurgeri), a echipamentelor și în jurul patului pacientului, folosind dezinfectanți eficienți (ex. produse pe bază de clor/hipoclorit de sodiu).
- Sterilizarea echipamentelor: Asigurarea sterilizării corecte a dispozitivelor și instrumentarului medical invaziv (catetere, tuburi de ventilație, sonde etc.) și manipularea aseptică a tuturor dispozitivelor invazive (schimbarea pansamentelor, manipularea cateterelor).
- Utilizarea rațională a antibioticelor: Limitarea utilizării prelungite sau nejustificate a antibioticelor, care pot selecta tulpini rezistente de Serratia.
Măsuri specifice de control al focarului (intervenții de urgență)
Eradicarea S. marcescens dintr-o secție ATI necesită o abordare strictă și multifactorială, bazată pe controlul sursei și întreruperea căilor de transmitere.
Odată ce un focar este declarat, se implementează măsuri sporite:
Investigarea surselor de apă
Prelevarea de probe microbiologice din chiuvete, sifoane, capete de duș și fântâni de apă. Dacă se confirmă colonizarea (biofilm), se impune inclusiv dezasamblarea și curățarea riguroasă a tuturor chiuvetelor și scurgerilor, decontaminarea chimică a sistemului hidric (ex. prin clorinare șoc) sau, în cazuri extreme, înlocuirea sifoanelor.
Izolarea contacților (Timpuriu)
Pacienții infectați sau colonizați sunt izolați în camere separate sau cohortați (grupați) în aceeași zonă/salon, cu personal medical dedicat (dacă este posibil), pentru a nu răspândi bacteria la alți pacienți.
Identificarea și eliminarea sursei
Pe baza rezultatelor tipizării moleculare și a screening-ului de mediu, se iau măsuri imediate: înlocuirea echipamentelor contaminate (sonde de ecocardiografie, ventilatoare, catetere), aruncarea soluțiilor contaminate (seringi pre-umplute, soluții IV) sau remedierea problemelor de infrastructură (sistemul de apă, chiuvetele).
Screening-ul pacienților
Screening-ul activ al tuturor pacienților expuși din secția afectată (de ex. prin tampoane rectale/faringiene) pentru a identifica și izola rapid purtătorii asimptomatici.
Igiena mâinilor intensificată
Reinstruirea de urgență a personalului și controale frecvente (și neanunțate) ale conformității cu igiena mâinilor.
Managementul personalului
Se poate lua în considerare screening-ul personalului, persoanele identificate ca purtători putand fi temporar redistribuite si/sau tratate.
Încheierea focarului
Focarul este considerat încheiat după o perioadă de timp fără niciun caz nou de infecție sau colonizare, după implementarea și evaluarea eficacității măsurilor de control.
Tratamentul infecțiilor cu Serratia marcescens
Tratamentul infecțiilor cu Serratia marcescens este complex și ridică dificultăți majore din cauza rezistenței intrinseci și dobândite a acestei bacterii la multe clase de antibiotice.
Principiul de bază este că tratamentul trebuie să fie ghidat întotdeauna de rezultatul antibiogramei tulpinii izolate de la pacient.
Rezistența intrinsecă a S. marcescens
Serratia marcescens este cunoscută pentru rezistența sa naturală (intrinsecă) la mai multe antibiotice comune, inclusiv:
- Penicilină
- Cefalosporine de generația I
- Macrolide, Tetracicline, Nitrofurantoin și Colistin
- β-lactamine
O amenințare majoră: Rezistența la Carbapeneme
Serratia marcescens poate deveni rezistentă la Carbapeneme (antibiotice de ultimă generație). Aceste tulpini multirezistente (CRSM) sunt extrem de greu de tratat, necesitând combinații complexe de medicamente, adesea toxice, și crescând semnificativ riscul de eșec terapeutic.
Opțiunile de tratament antibiotic (Ghidate de antibiogramă)
Tratamentul de primă intenție pentru infecțiile severe se concentrează pe antibioticele la care bacteria este cel mai frecvent sensibilă:
- Carbapeneme - Sunt adesea considerate cele mai eficiente, în special pentru infecțiile severe, invazive (sepsis, meningită, pneumonie) sau când se suspicionează rezistența.
- Cefalosporine - Pot fi folosite ca tratament de primă linie sau în combinație, dar eficacitatea lor depinde de sensibilitatea confirmată.
- Aminoglicozide - Adesea utilizate în combinație cu un alt antibiotic (Carbapenem sau Cefalosporină de generația a III-a/a IV-a) pentru infecțiile severe (terapie empirică inițială).
- Fluorochinolone - Pot fi eficiente, dar utilizarea lor trebuie confirmată de antibiogramă.
- Cotrimoxazol (Trimetoprim-Sulfametoxazol) - Poate fi o opțiune pentru infecțiile mai puțin complicate, în special infecțiile urinare, dacă tulpina este sensibilă.
- Combinatii noi - Rezervate pentru tulpinile care prezintă rezistență la Carbapeneme
Abordarea terapeutică
- Terapia empirică (inițială): Dacă infecția este severă (ex. septicemie) și rezultatul antibiogramei nu este disponibil, medicii inițiază un tratament cu spectru larg care acoperă și S. marcescens, adesea o combinație (ex. un Carbapenem sau o Cefalosporină de generația a IV-a plus un Aminoglicozid).
- Terapia țintită (definitivă): Imediat ce rezultatul antibiogramei devine disponibil, tratamentul este ajustat la cel mai eficient antibiotic la care tulpina este sensibilă. Acest lucru este vital pentru a evita rezistența și a optimiza tratamentul.
- Măsuri suplimentare:
Înlăturarea dispozitivelor: Dacă infecția este asociată cu un dispozitiv medical (cateter venos central, sondă urinară, tub de ventilație), acesta trebuie îndepărtat sau înlocuit pentru a elimina sursa de biofilm bacterian, care este adesea foarte rezistent la antibiotice.
Drenajul colecțiilor: Dacă există abcese sau colecții purulente, acestea necesită drenaj chirurgical.
Concluzie: Serratia marcescens este o amenințare serioasă în mediul intraspitalicesc, fiind un patogen oportunist, de multe ori multirezistent (MDR - Multi-Drug Resistant). Tratamentul este exclusiv medical și se stabilește de către un medic infecționist, în funcție de severitatea bolii, locul infecției și profilul specific de rezistență al tulpinii izolate.
Prognosticul si rata de mortalitate în cazul complicațiilor S. marcescens
Prognosticul pacienților depinde critic de starea generală a acestora, dar și de rapiditatea instituirii tratamentului adecvat.
Factori de risc pentru agravarea prognosticului
Anumite circumstanțe sunt agravante, ducând la un prognostic nefast în cazul infectării nosocomiale cu S. Marcescens:
- infecțiile la nou-născuții prematuri;
- pacienții cu afecțiuni severe subiacente;
- pacienții la care tratamentul este întârziat;
- vârsta înaintată;
- prezența șocului septic;
- rezistența bacteriei la antibiotice. S. marcescens este cunoscută pentru rezistența sa intrinsecă și dobândită la numeroase clase de antibiotice, ceea ce face tratamentul dificil.
Recuperarea: Poate dura de la câteva săptămâni la câteva luni.
Rata de mortalitate asociată infecțiilor invazive cu S. marcescens este semnificativă, variind în funcție de grupul de pacienți și tipul de infecție:
Rata de mortalitate prin bacteriemie (infecție în sânge):
- La populația adultă, mortalitatea raportată în cazurile de bacteriemie (sepsis) cu S. marcescens variază între 10% și 37%, ajungând în unele studii chiar la 25-58%.
- În cazul pacienților vârstnici cu comorbidități, mortalitatea poate depăși 22% în decurs de o lună de la diagnosticarea bacteriemiei.
Rata de mortalitate neonatală: În focarele de infecții cu S. marcescens din secțiile de Terapie Intensivă Neonatală (TIN), rata de mortalitate a fost raportată în jurul valorii de 7% până la 44% în unele studii.
Cum prevenim infectiile cu Serratia Marcensens?
Având în vedere rezistența și mortalitatea ridicată asociate cu Serratia marcescens, prevenția este vitală. Măsurile se concentrează pe controlul sursei din mediu și pe igienă.
Măsuri pentru personalul medical și unitatea sanitară
- Igiena riguroasă a mâinilor: Este cea mai importantă măsură. Trebuie respectată strict, utilizând soluții pe bază de alcool, înainte și după orice contact cu pacientul sau cu mediul acestuia.
- Controlul surselor de apă: Monitorizarea microbiologică a chiuvetelor și sifoanelor din ATI/TIN. Dacă se detectează colonizare, se impune decontaminarea chimică (clorinare șoc) sau, la nevoie, înlocuirea sistemelor hidrice.
- Dezinfectarea suprafațelor: Utilizarea unor dezinfectanți eficienți, la concentrații corecte, care să fie activi împotriva tulpinilor rezistente la amoniu cuaternar.
- Managementul dispozitivelor invazive: Scoaterea cateterelor, sondelor urinare sau tuburilor de ventilație imediat ce nu mai sunt necesare.
Măsuri pentru pacienți și vizitatori
- Spălatul pe mâini des și corect: Spălați-vă mâinile cu apă și săpun înainte de a mânca, după folosirea toaletei și după ce ați atins suprafețele din salon. Aceasta este cea mai simplă și eficientă metodă de prevenție.
- Atenție la curățenie: Nu atingeți direct suprafețele umede sau sifoanele din toalete și chiuvete.
- Adresați întrebări: Nu ezitați să cereți personalului medical să se spele pe mâini sau să folosească dezinfectantul înainte de a vă atinge sau de a începe o procedură.
- Comunicați: Informați rapid personalul medical în legătură cu orice problemă a pansamentelor sau a dispozitivelor medicale (catetere, tuburi).
- Urmați tratamentul: Dacă sunteți diagnosticat cu Serratia, luați antibioticele exact cum v-a prescris medicul, pe toată durata recomandată. Oprirea tratamentului prea devreme favorizează apariția rezistenței.
Infecțiile cu Serratia marcescens sunt un indicator clar al problemelor din sistemul sanitar, în primul rând, o problemă de control al infecțiilor nosocomiale. Înțelegerea modului în care se răspândește – plecând de la un simplu sifon și ajungând la un pacient vulnerabil – este primul pas spre protecția pacienților. De aceea, respectarea riguroasă a protocoalelor de igienă și monitorizarea atentă a mediului spitalicesc reprezintă cheia pentru prevenirea răspândirii acestei bacterii periculoase, precum și a altor agenți patogeni nosocomiali care pun în pericol viața pacienților fragili, spitalizati in sectiile de ATI.
Bibliografie:
- Datele ECDC (European Centre for Disease Prevention and Control), conform rapoartelor anuale de supraveghere a infecțiilor dobândite în secțiile de terapie intensivă (HAI-Net ICU).
- "Risk Factors for Mortality in Patients with Serratia marcescens Bacteremia" https://pmc.ncbi.nlm.nih.gov/articles/PMC4329343/
- "Current Epidemiological Status and Antibiotic Resistance Profile of Serratia marcescens" (https://pubmed.ncbi.nlm.nih.gov/38666999/
- "Serratia marcescens Infections in Neonatal Intensive Care Units (NICUs)" https://pmc.ncbi.nlm.nih.gov/articles/PMC6406414/
- "A long-term survey of Serratia spp. bloodstream infections revealed an increase of antimicrobial resistance involving adult population" (Publicat în PubMed Central)
- “Epidemiology of Serratia bloodstream infections among hospitalized children in the United States, 2009-2016”. Johnson A et al. 2020. Pediatr Infect Dis J 39:e71–e73.